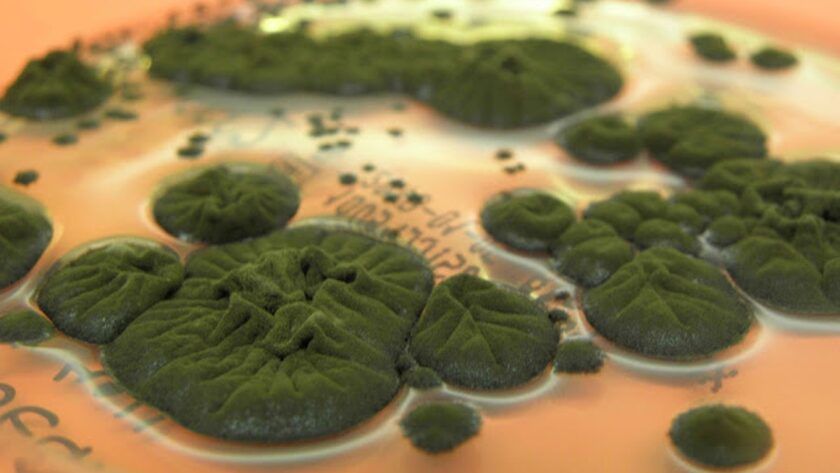

Tajemná černá houba objevená v Černobylu
Vědci zkoumají záhadnou černou houbu, která byla odkryta v jedné z nejradioaktivnějších struktur na Zemi: troskách reaktoru č. 4 v Černobylu. Organismus Cladosporium sphaerospermum nejenže odolává intenzivnímu záření, ale zdá se, že roste ještě lépe v jeho přítomnosti, což odporuje starým předpokladům o tom, jak se život přizpůsobuje extrémním podmínkám.
Tato houba, bohatá na melanín, byla nalezena na konci 90. let během studie prováděné v Zóně vyloučení kolem Černobylu. Vědci zdokumentovali 37 druhů hub v úkrytu reaktoru, přičemž C. sphaerospermum dominovalo vzorkům i přes extrémně vysoké úrovně kontaminace.
Laboratorní experimenty následně ukázaly, že ionizující záření (které obvykle poškozuje nebo ničí živé tkáně) podněcuje růst houby namísto toho, aby ho inhibovalo. Studie z roku 2008 navrhla, že houba by mohla provádět „radiosyntézu“, proces podobný fotosyntéze, při kterém melanín přetváří záření na využitelnou biochemickou energii.
Ačkoliv experimenty ukazují, že záření mění chování melanínu a poskytuje mu ochrannou roli, vědci dosud neprokázali skutečný mechanismus zachytávání energie nebo proces fixace uhlíku. Zájem o tuto oblast ještě více vzrostl v roce 2022, kdy byly vzorky poslány na Mezinárodní vesmírnou stanici. Tam melanizované houby blokovaly více kosmického záření než kontrolní vzorky, což naznačuje jejich potenciální využití jako biologické štítu pro vesmírné mise.
Přesto zůstává přesný mechanismus odolnosti houby neznámý, což otevírá otázku, zda se jedná o skutečnou adaptaci nebo pouze o sofistikovanou reakci na stres.